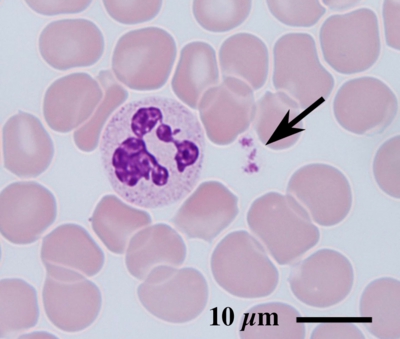

血小板:ペレット作製法
Preparation of Platelet-Pellet
ヒト末梢血から血小板を分離し、透過型電子顕微鏡で観察するプロトコールをご紹介します。
はじめに、抗凝固剤(クエン酸ナトリウム)を含む真空採血管(4.5 ml)に採血された血液から血小板を遠心分離します。

遠心分離前の全血には細胞成分の赤血球や白血球、血小板のほか、液体成分の血漿が混在しています。
血小板(矢印)の直径は僅か1〜2 µmしかなく、光学顕微鏡では点状に観察されるのみです。
真空採血管に入った全血を 200 g で5分間、スイングローターで遠心分離すると、赤血球が沈殿し、黄色い血漿が上清として分離されます。

先の細いスポイトで赤血球が混入しないよう慎重に血漿を採取し、1.5 mlのエッペンドルフチューブに入れます。

採取した血漿を900 g で5分間、遠心分離すると血小板ペレットが沈殿します。

次に血小板ペレットを固定し、樹脂包埋へ進みます・・・血小板:ペレット固定法へ